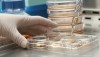

Portuguese American Journal
Archive | August, 2011

Exhibit: “Visualizing Lisbon’s Traffic” – MoMA, NYC
Posted on 03 August 2011.
Posted in Arts&Culture, Featured, People

Earthquake magnitude 4.1 rattles Faial – Azores
Posted on 03 August 2011.
Posted in Azores, Faial, Featured, Pico, São Jorge, Terceira

Terceira: 27th International Folklore Festival – Azores
Posted on 02 August 2011.
Posted in Azores, Entertainment, Featured, Heritage, Organizations, Terceira
Portuguese researchers disclose bacterial resistance to antibiotics – Portugal
Posted on 02 August 2011.

Annual Convention of Portuguese Organizations – Maui, Hawaii
Posted on 01 August 2011.
Posted in Azores, Cape Verde, Community, Conferences, Education, Faial, Graciosa, Heritage, Madeira, Organizations, São Jorge

Portuguese food and wine at the Society of Wine Educators Conference – RI
Posted on 01 August 2011.
Posted in Conferences, Featured, Food & Wine, Heritage, Organizations, World

